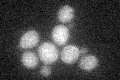
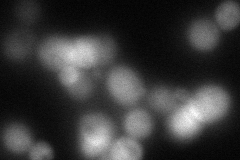
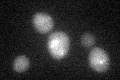

View description
Triacylglycerol lipase that is localized to the mitochondria; has lipolytic activity towards triacylglycerols and diacylglycerols when expressed in E. coli
Localization:
Intensity:
Fold change:
Significance:
-
C’ GFP library in SD
below threshold17.67 -
N' NOP1pr-GFP in SD

cytosol,punctate60.2996 -
N' TEF2pr-mCherry in SD
cytosolN/A -
N' NATIVEpr-GFP in SD

ambiguous16.9862 -
N' TEF2pr-VC and Cyto-VN in SD

below threshold26.4733 -
C’ GFP library in SD+DTT
cytosol19.331.09No -
C’ GFP library in SD+H2O2

cytosol16.680.94No -
C’ GFP library in Starvation Media

cytosol14.230.8No -
C’ GFP library on the background of Pup2-DaMP

below threshold -
C’ GFP library on the background of CCT mutant

below threshold21.28321.20407No
